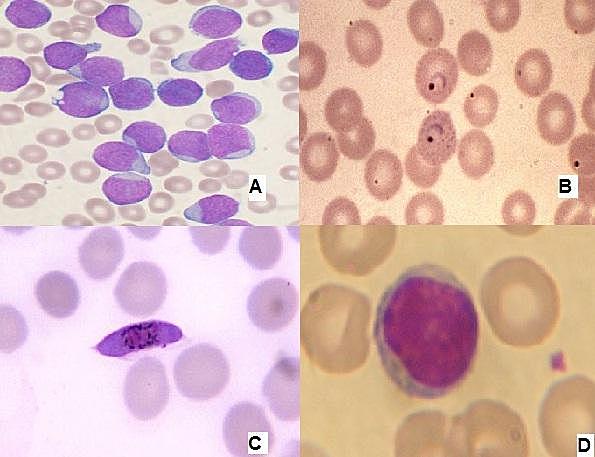
TINCION DE GRAM

-
Aunque el origen del microscopio es una cuestión aún incierta, se le considera a Zacharias Lansen como el inventor del microscopio compuesto (con dos lentes).
-
Francesco Redi demostró que los insectos no nacen por generación espontánea, por lo que se le considera el fundador de la helmintología (el estudio de los gusanos). Realizó estudios sobre el veneno de las víboras, y escribió Observaciones en torno a las víboras .
-
Antonie Van Leeuwenhoek, Fue el primero en realizar importantes observaciones con microscopios fabricados por él mismo. Desde 1674 hasta su muerte realizó numerosos descubrimientos. Fue el precursor de la biología experimental, la biología celular y la microbiología
-
Francesco Redi. Utiliza unos botes de cristal con trozos de carne, dichos botes los tapa con unas gasas que permiten el paso del aire pero de nada más, entonces no se generan "animáculos" en estos trozos de carne. La solución está en las larvas que son depositadas por moscas que se posaban en la carne, en los botes sin tapar, y hacían posible la aparición de esos "animáculos".
-
Le apasionó el problema de la regeneración espontánea de partes del cuerpo de anfibios y de reptiles aunque no pudo llegar a conclusiones satisfactorias, sobre todo no pudo explicar el por qué no sucedía lo mismo en el ser humano y en otros animales.
-
La teoría microbiana fue muy controvertida en sus inicios, hoy en día es fundamental en la medicina moderna y la microbiología clínica y condujo a innovaciones tan importantes como el desarrollo de vacunas, los antibióticos, la esterilización y la higiene como métodos efectivos de cura y prevención contra la propagación de las enfermedades infecciosas.
-
Propuso la clasificación de las bacterias: género, especie y variedades, y también escribió otros microorganismos patógenos transmitidos por agua contaminada.
-
Fue un microbiólogo alemán a quien se le atribuye la invención de la placa de Petri, En 1877 cuando inventó la placa Petri. Esta se utiliza en los laboratorios principalmente para el cultivo de microorganismos, soliéndose cubrir el fondo con distintos medios sólidos de cultivo según el microorganismo que se quiera cultivar.
-
Es la tinción diferencial empleado en bacteriología para la visualización de bacterias, sobre todo en muestras clínicas. Debe su nombre al bacteriólogo danés Christian Gram, que desarrolló la técnica en 1884. Se utiliza tanto para poder referirse a la morfología celular bacteriana, como para poder realizar una primera aproximación a la diferenciación bacteriana, considerándose bacterias gram positivas a las que se visualizan de color morado, y bacterias gram negativas.
-
Las bacterias pueden tener cromosomas lineales o circulares.
Plan projects on a visual timeline
Map milestones, phases, deadlines, and key events in one place so the sequence is easier to see and share. Timetoast is a timeline maker for work, school, research, and stories.